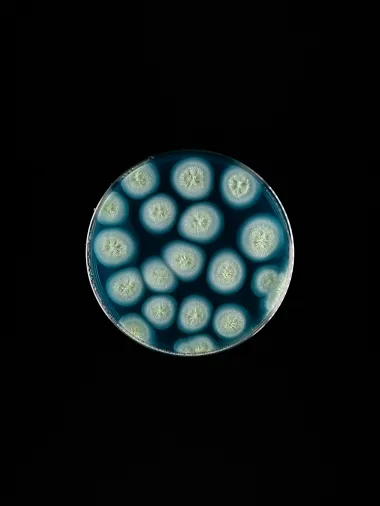
glaciers

The United Nations has declared 2025 the International Year of the Conservation of Glaciers to highlight the critical role glaciers, snow, and ice play in regulating the planet’s climate. Globally, glaciers are shrinking at an alarming rate, leading to rising sea levels, coastal erosion, and water shortages in certain regions.
According to Dr. Frey from the Swiss Federal Institute for Forest, Snow, and Landscape Research (WSL), glacier loss extends beyond melting ice, as it also means the disappearance of microorganisms preserved for centuries or millennia.
Mountains such as Mt. Kenya, Mt. Kilimanjaro, and Mt. Everest have experienced significant ice loss over the last two decades due to global warming. This process has begun releasing microorganisms trapped in glaciers. Unfortunately, many of these microbes fade away without being identified or studied, representing a missed opportunity to understand their potential contributions to science.
A study by the Swiss Federal Institute of Technology Zurich and the Vrije Universiteit Brussel predicts that, in a low-emission scenario, the world’s 200,000+ glaciers (excluding those in Greenland and Antarctica) will lose 29% of their volume by 2100. However, under high-emission scenarios, this loss could reach 54%. Dr. Frey warns that with these glaciers, humanity is losing a vast biological heritage, including organisms that could help us understand life in extreme cold conditions.
Rising global temperatures and erratic weather patterns have accelerated glacial melting. Glacial melting at a sped-up rate has proven a critical threat to the environment. Swiss glaciers, including the Rhone Glacier, have lost more than 60% of their volume since 1850.
The annual melt rate between 2023 and 2024 reached 2.5%, surpassing the decade’s average. Without urgent reductions in greenhouse gas (GHG) emissions, most Alpine glaciers could vanish by the end of this century.
Glaciers Microorganisms Unlocking Medicinal and Environmental Solutions
Glaciers harbor thousands of microbial species, many of which remain largely unknown. These include bacteria, viruses, and fungi—some potentially pathogenic, while others possess remarkable medicinal properties. For example, Chinese researchers recently identified more than 10,000 microbial species in the ice of the Tibetan Plateau.
Joh Priscu of Montana State University highlights that microorganisms, among the planet’s oldest life forms, provide valuable insights into past climate changes. Additionally, these microbes could inspire innovative medical and biotechnological solutions.
Recent discoveries have revealed bacteria and fungi capable of breaking down plastic at low temperatures, a breakthrough in the fight against pollution. By preserving microbial biodiversity in glaciers, scientists can study these organisms and their properties. Some bacteria, for instance, may produce new molecules with anticancer, antibiotic, or antioxidant properties, offering hope in addressing global health challenges.
Antibiotic resistance, described by the United Nations as a “silent pandemic,” is among the top 10 global health threats, claiming over 1.2 million lives annually—more than HIV or malaria. Bacteria of the Streptomyces genus, already known for producing antibiotics, are promising candidates for further research.
Moreover, bacteria isolated from glaciers in the Swiss Alps and the Arctic have been shown to degrade plastics such as polyurethane and polybutylene adipate terephthalate at temperatures as low as 15°C. These enzymes could one day be used in bioreactors to break down plastics, addressing one of the planet’s most pressing environmental challenges.
The rapid loss of glaciers is a testament to the urgency of global efforts to combat climate change and preserve Earth’s biological heritage. From medicinal discoveries to plastic-eating enzymes, microorganisms trapped in glaciers hold untapped potential that could benefit humanity in significant ways.
Protecting this biodiversity is an environmental imperative and an opportunity to advance science and address some of the world’s greatest challenges. How can our African scientists be incentivized and supported to research our climate-impacted ecosystems? The research will enable a detailed understanding of the changes we are witnessing by granting us a clue about the past.

